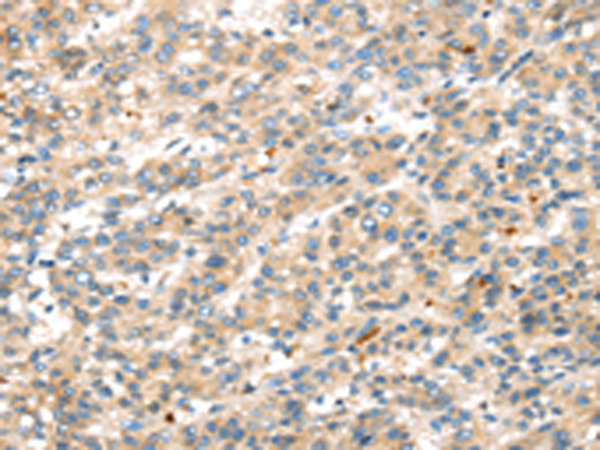

|
Background: |
This gene encodes a protein that is a member of the dickkopf family. It is a secreted protein with two cysteine rich regions and is involved in embryonic development through its inhibition of the WNT signaling pathway. Elevated levels of DKK1 in bone marrow plasma and peripheral blood is associated with the presence of osteolytic bone lesions in patients with multiple myeloma. |
|
Applications: |
ELISA, IHC |
|
Name of antibody: |
DKK1 |
|
Immunogen: |
Synthetic peptide of human DKK1 |
|
Full name: |
dickkopf WNT signaling pathway inhibitor 1 |
|
Synonyms: |
SK; DKK-1 |
|
SwissProt: |
O94907 |
|
ELISA Recommended dilution: |
2000-5000 |
|
IHC positive control: |
Human liver cancer and Human brain |
|
IHC Recommend dilution: |
25-100 |
購物車
購物車 幫助
幫助
 021-54845833/15800441009
021-54845833/15800441009
